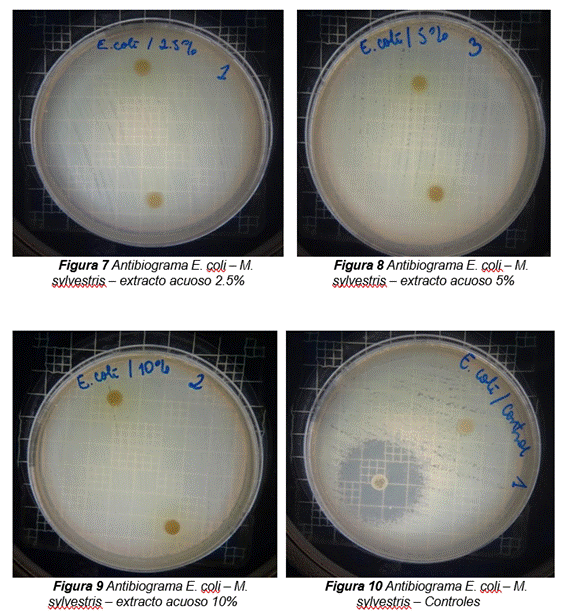
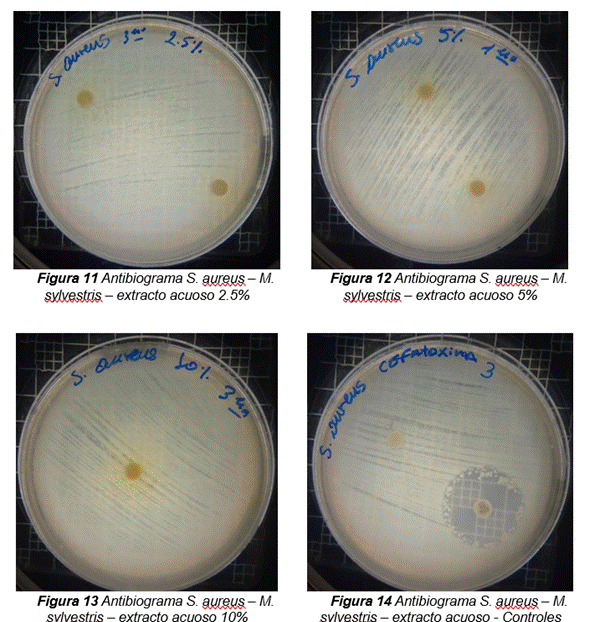
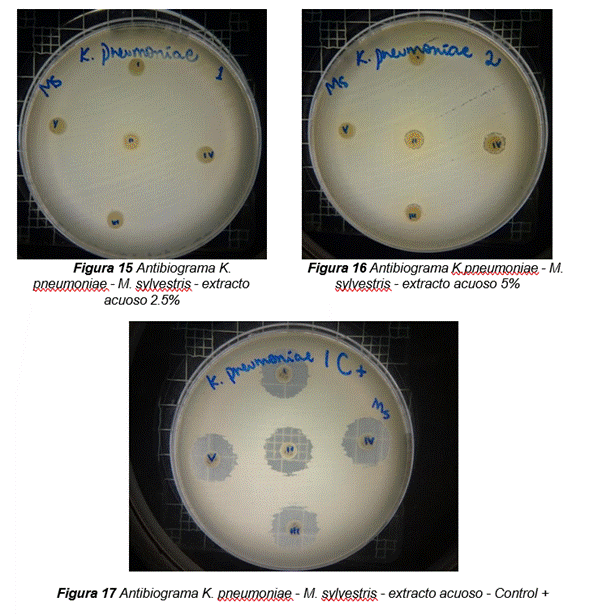
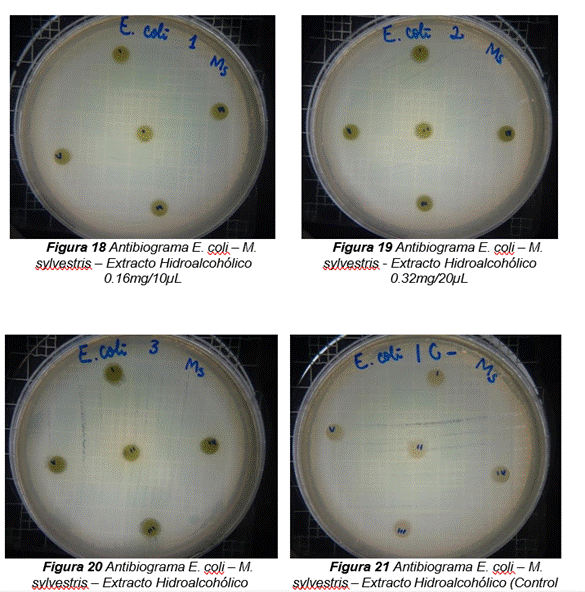
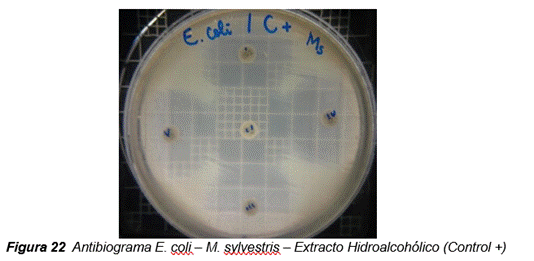
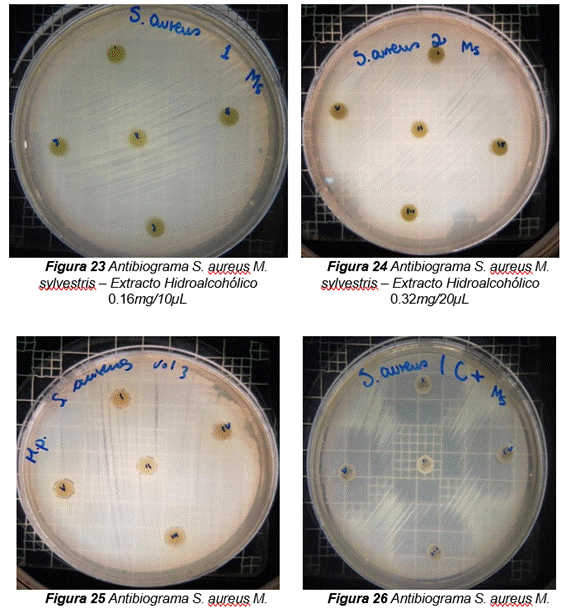
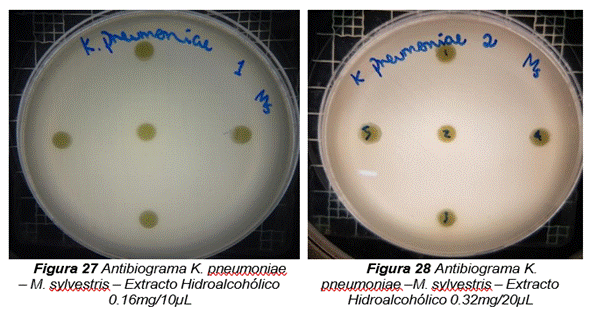
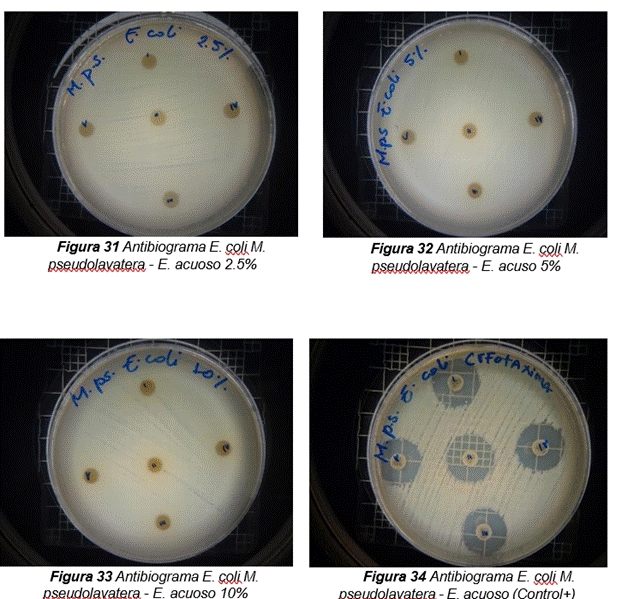
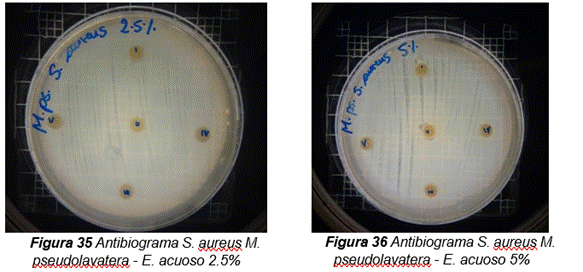
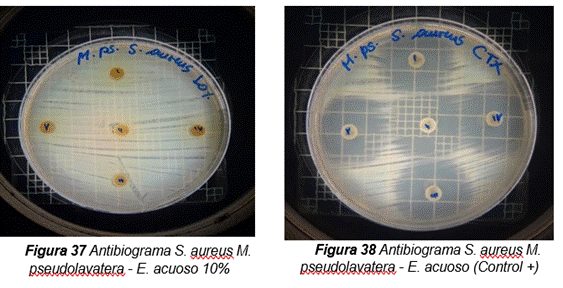
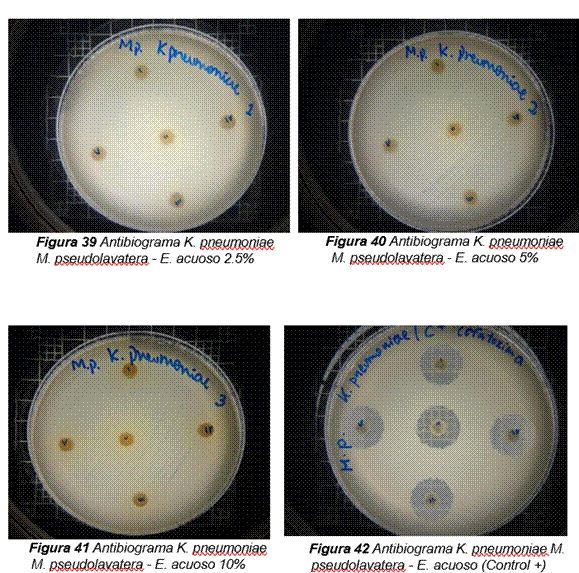
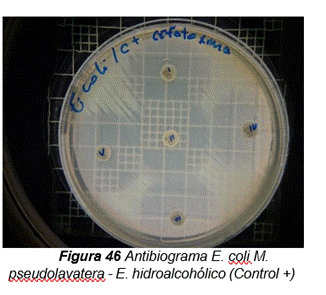
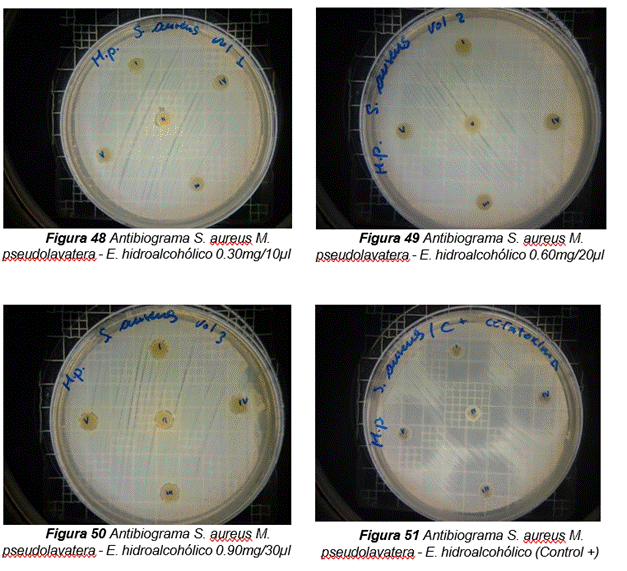
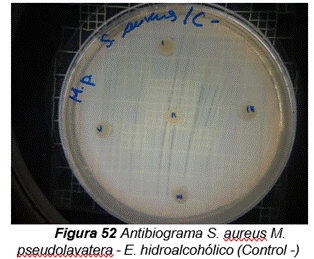
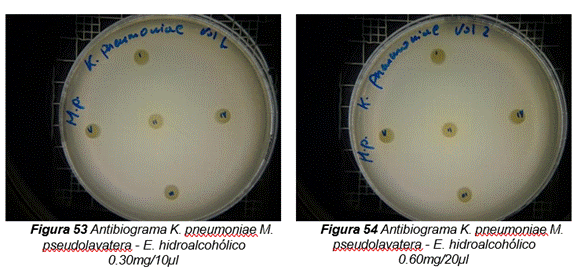
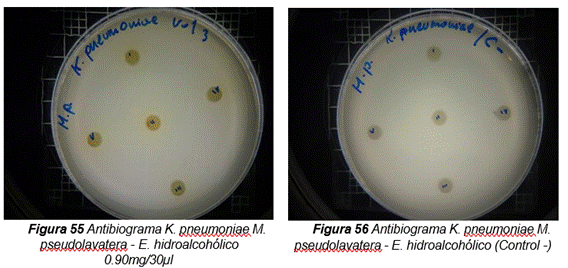
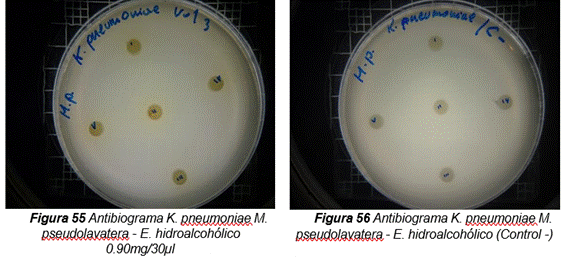

doi: 10.56294/hl2024.519
ORIGINAL
In Vitro Evaluation of the Antibacterial and Antioxidant Activity of Malva Sylvestris and Malva Pseudolavatera Malva Extracts
Evaluación in Vitro de la Actividad Antibacteriana y Antioxidante de los Extractos de Malva Sylvestris y Malva Pseudolavatera
Yesenia Anabell Abrigo Alvarado1, Nixon Michael Goyes García1, Patricia Jiménez Granizo1, Glenda Sarmiento Tomalá1
1Universidad de Guayaquil, Facultad de Ciencias Químicas y Farmacia. Guayaquil, Ecuador.
Citar como: Abrigo Alvarado YA, Goyes García NM, Jiménez Granizo P, Sarmiento Tomalá G. In Vitro Evaluation of the Antibacterial and Antioxidant Activity of Malva Sylvestris and Malva Pseudolavatera Malva Extracts. Health Leadership and Quality of Life. 2024; 3:.519. https://doi.org/10.56294/hl2024.519
Enviado: 05-04-2024 Revisado: 07-08-2024 Aceptado: 22-11-2024 Publicado: 23-11-2024
Editor: PhD.
Prof.
Neela Satheesh ![]()
ABSTRACT
In the present research work has done the evaluation of the antibacterial activity of aqueous and hydroalcoholic extracts of the leaves of Malva sylvestris and Malva pseudolavatera, against three microorganisms (Escherichia coli, Staphylococcus aureus, Klebsiella pneumoniae) and antioxidant evaluation of hydroalcoholic extracts, with the goal to provide an alternative in the treatment of infectious and chronic degenerative diseases. The antibacterial activity was performed by disk diffusion assays using Cefotaxime as a reference antibiotic; The antioxidant activity was carried out by three in vitro methods, the method of FRAP (ferro-reducing capacity), 2,2-diphenyl-1-picrylhydracil (DPPH) and 2,2’- azino-bis (3-ethylbenzothiazoline)-6-sulfonic (ABTS•+). The results obtained indicated that the analyzed extracts of both Malva species showed a moderate antibacterial activity in certain concentrations against the microorganisms E. coli, S. aureus and K. pneumoniae; and taking into account the results of the antioxidant activity in the three in vitro methods tested, it was I observed that as the concentration of the extracts increased, the reducing power (FRAP test) and the anti-radicals activity (DPPH and ABTS•+ tests) increased as well, manifesting a high antioxidant activity. As a consequence of this, we can conclude that Malva sylvestris and Malva pseudolavatera leaf extracts produce inhibition halos in the strains of the microorganisms evaluated (E. coli, S. aureus, K. pneumoniae), in addition to presenting inhibition of the radicals used (DPPH, ABTS•+) and ferro- reducing capacity (FRAP).
Keywords: Antibacterial; Antioxidant; Malva Sylvestris; Malva Pseudolavatera; Free Radicals.
RESUMEN
En el presente trabajo de investigación se realizó la evaluación de la actividad antibacteriana de extractos acuosos e hidroalcohólicos de las hojas de Malva sylvestris y Malva pseudolavatera, contra tres microorganismos (Escherichia coli, Staphylococcus aureus, Klebsiella pneumoniae) y la evaluación antioxidante de los extractos hidroalcohólicos, con la finalidad de brindar una alternativa en el tratamiento de enfermedades infecciosas y crónico-degenerativas. La actividad antibacteriana se realizó por ensayos de difusión en discos utilizando Cefotaxima como antibiótico de referencia; la actividad antioxidante se llevó a cabo mediante tres métodos in vitro, el método de FRAP (capacidad ferroreductora), 2,2-difenil- 1-picrilhidracilo (DPPH) y ácido 2,2’-azino-bis (3-etilbenzotiazolina)-6-sulfónico (ABTS•+). Los resultados obtenidos indicaron que los extractos analizados de ambas especies de Malva presentaron una actividad antibacteriana moderada en determinadas concentraciones frente a los microorganismos E. coli, S. aureus y K. pneumoniae; y teniendo en consideración los resultados de la actividad antioxidante en los tres métodos in vitro ensayados se pudo constatar que a medida que aumentaba la concentración de los extractos, aumentaba el poder reductor (ensayo FRAP) y la actividad antirradicalaria (ensayos DPPH y ABTS•+) de los mismos, manifestándose una elevada actividad antioxidante. Como consecuencia de esto, podemos concluir que los extractos de las hojas de Malva sylvestris y Malva pseudolavatera producen halos de inhibición en las cepas de los microorganismos evaluados (E. coli, S. aureus, K. pneumoniae), además de presentar inhibición de los radicales empleados (DPPH, ABTS•+) y capacidad ferro-reductora (FRAP).
Palabras clave: Antibacteriana; Antioxidante; Malva Sylvestris; Malva Psedolavatera; Radicales Libres.
INTRODUCCIÓN
Actualmente el uso de las plantas medicinales ha tomado mayor relevancia en las poblaciones rurales debido a que presentan una contribución muy importante en el sistema de salud.(1,2,3,4,5,6) Ecuador se ha convertido en uno de los países con gran potencial en la medicina tradicional ya que tiene muchas variedades de plantas con muchos beneficios curativos que podrían ser utilizados para el tratamiento de múltiples enfermedades en las diferentes comunidades del país.(7,8,9,10,11)
Se han realizado algunos estudios sobre la planta de Malva, en especial de la especie sylvestris,(12,13,14,15) en donde se ha evaluado diferentes acciones farmacológicas y se ha podido observar que esta planta tiene acción antiinflamatoria, digestiva, antioxidante y cicatrizante, todo esto gracias a que posee varios metabolitos secundarios con gran actividad farmacológica, entre estos están: alcaloides, flavonoides, mucílagos, quinonas, saponinas, taninos, resinas, entre otros.(16,17,18,19,20)
En los últimos años, las enfermedades infecciosas en piel y tejidos son un problema para los diferentes sitios de salud pública, en donde se emplea antibióticos como tratamiento, que en muchas ocasiones no siempre son administrados de forma adecuada y las infecciones persisten dando origen una resistencia bacteriana en el paciente tratado.(21,22,23,24,25)
Debido a la resistencia antibacteriana que presentan muchos pacientes por el uso incorrecto de antibióticos, la Organización Mundial de la Salud (OMS) considera el tratamiento de las enfermedades infecciosas con antibióticos un verdadero problema de salud pública que puede afectar a cualquier persona.(26,27,28)
Como consecuencia de este fenómeno, enfermedades bacterianas que actualmente pueden ser tratadas podrían volverse incontrolables y propagarse de manera rápida a nivel global, por lo que se requiere corregir el uso incorrecto de antibióticos y a su vez emplear como alternativa el uso de plantas medicinales que puedan contribuir en el tratamiento de infecciones causadas por distintos microorganismos.(29,30,31,32)
Por otra parte, debido a la presencia de ciertos metabolitos en plantas del género Malva es que se ha optado por evaluar también su actividad antioxidante para evitar la formación de radicales libres derivados de oxígeno, los cuales son causantes de diversas enfermedades crónico-degenerativas en los seres humanos y son de relevancia clínica significativa. Los radicales libres son moléculas químicas que presentan un electrón en el orbital externo libre, y esto produce una configuración espacial poco estable; son muy reactivos y tienen una vida media corta.(33,34,35,36)
Los seres humanos poseen sistemas de defensa naturales (antioxidantes) dentro del organismo que impiden que se generen efectos nocivos por la presencia de los radicales libres, neutralizándolos. Sin embargo, cuando hay un déficit de antioxidantes en el organismo, no tienen la capacidad de equilibrar los radicales libres y estos pueden provocar efectos dañinos, como lo es el estrés oxidativo (daño celular).(37,38,39,40)
En el presente trabajo se pretende emplear dos especies del género Malva, sylvestris y pseudolavatera, para evaluar su actividad antibacteriana y antioxidante, realizando una comparación entre ambas y a su vez brindar una alternativa en el tratamiento de enfermedades infecciosas y cancerígenas.
¿Cuáles serán los diámetros de los halos de inhibición y disminución de radicales libres que presentan los extractos de Malva sylvestris y Malva pseudolavatera?
Objetivo
Evaluar la actividad antibacteriana y antioxidante de los extractos de Malva sylvestris y Malva pseudolavatera en diferentes concentraciones.
MÉTODO
Tipo de investigación
La investigación es de carácter hipotético, cuantitativo y experimental, sobre la actividad antibacteriana y antioxidante de Malva sylvestris y Malva pseudolavatera. Debido que al inicio del estudio se planteó una hipótesis, el cual a través de la experimentación de los ensayos in vitro y cuantificación de los resultados obtenidos será aceptada o rechazada, indicando si alguna de las dos especies de Malva presenta actividad antibacteriana o antioxidante.
Equipos, Materiales y Reactivos
Equipos
|
Tabla 1. Equipos utilizados en el análisis |
|
|
Equipos utilizados para la actividad antibacteriana |
Equipos utilizados para la actividad antioxidante |
|
Molino eléctrico marca IKA MF10 BASIC Balanza analítica marca Shimadzu Incubadora marca memmert Contador de colonias manual de campo oscuro marca Reichert Technologies Regriferadora marca Durex |
Espectrofotómetro UV-visible marca Thermo Spectronic modelo Genesys 20 |
Materiales

Figura 1. Materiales usados
Material vegetal y biológico
|
Tabla 2. Material vegetal y biológico |
|
|
Material vegetal |
Material biológico |
|
Malva sylvestris Malva pseudolavatera |
Cepas de Escherichia coli ATCC 25922 Cepas de Staphylococcus aureus ATCC 25923 Cepas de Klebsiella pneumoniae ATCC 700603 |
Reactivos
|
Tabla 3. Reactivos que se utilizaron en el análisis |
|||
|
Actividad antibacteriana |
Actividad antioxidante |
||
|
Etanol Caldo de infusión cerebro corazón (BHI) Reactivo de Mcfarland Suero fisiológico Discos de Cefotaxima 30 mcg Discos blancos |
FRAP |
DPPH |
ATBS |
|
Acetato de sodio anhidro Ácido acético (99,7 %) 2,4,6-tripiridil-s- triazina (TPTZ) Ácido clorhídrico (37 %) FeCl3 FeSO4 x 7 H2O (sustancia de referencia) Ácido ascórbico (99 % pureza), (sustancia de referencia) |
DPPH (2,2difenil-1- picrilhidracilo) Etanol absoluto Ácido ascórbico (99 % pureza) (sustancia de referencia) Trolox (sustancia de referencia) |
ABTS (ácido2,2’-azino-bis(3-etilbenzotiazolina)-6-sulfónico) Persulfato de potasio Etanol al 96 % Ácido ascórbico (99 % pureza) (sustancia de referencia) |
|
Muestra
|
Tabla 4. Muestra: actividad antibacteriana y antioxidante |
|||
|
Actividad antibacteriana |
Actividad antioxidante |
||
|
Extractos acuosos de Malva sylvestris y Malva pseudolavatera al 2,5 – 5 y 10 %. |
FRAP |
DPPH |
ATBS |
|
Extractos hidroalcohólicos al 80 % de Malva sylvestris y Malva pseudolavatera |
|||
|
Extractos hidroalcohólicos de Malva sylvestris (0,16 mg/10µL – 0,32 mg/20µL y 0,48 mg/30µL) y Malva pseudolavatera (0,30 mg/10µL – 0,60 mg/20µL y 0,90 mg/30µL) |
Concentraciones: 25, 50, 100, 150 y 200 µg/mL |
Concentraciones: 100, 200, 300, 400 y 500 µg/mL |
|
Metodología Experimental

Figura 2. Metodología de la actividad antimicrobiana y antioxidante
Recolección y selección de especies de Malva
La recolección de las especies vegetales constituidas por Malva sylvestris y Malva pseudolavatera, fueron obtenidas en la provincia de Chimborazo, cantón Guano y seleccionadas con el fin de establecer una comparación de la actividad antibacteriana y antioxidante de ambas especies.
Secado de las especies vegetales
Las dos especies de Malva fueron previamente limpiadas de sus impurezas y se procedió a exponerlas a un secado natural sin exposición del sol.
Pulverización y almacenamiento
Luego del secado natural, se deshojó las plantas de ambas especies, las hojas se llevaron a la estufa por un periodo de 2h a 50ºC. Posteriormente las hojas fueron trituradas en el molino eléctrico marca IKA MF10 BASIC a 3500 rpm. Una vez obtenido el pulverizado de ambas especies se dejaron almacenadas en funda ziploc a temperatura de refrigeración, para luego ser utilizado en la obtención del extracto hidroalcohólico.
Obtención del extracto acuoso de ambas especies
A partir de las muestras vegetales liofilizadas de Malva sylvestris y Malva pseudolavatera, se procedió a pesar la cantidad necesaria para las concentraciones establecidas (2,5 %, 5 % y 10 %) y para su disolución se empleó agua destilada. El extracto fue preparado el mismo día del análisis.
Obtención del extracto hidroalcohólico de ambas especies
A partir de las muestras vegetales pulverizadas de Malva sylvestris y Malva pseudolavatera, se procedió a pesar 50 g de polvo de cada una de las especies, se la humectó con 60 mL de solución hidroalcohólica (50:50) y se dejó macerar durante 48 horas con 150 mL de la misma solución hidroalcohólica a temperatura ambiente. Luego se filtró, se midió el volumen obtenido y se calculó su concentración.
Cálculo de la concentración de los extractos
Para calcular la concentración se tomó una alícuota de 5 mL, se la colocó en una cápsula previamente tarada, se dejó evaporar a sequedad en baño de agua y se pesó nuevamente.
Actividad antibacteriana
La evaluación de la actividad antibacteriana de los extactos obtenidos de Malva sylvestris y Malva pseudolavatera, se realizó mediante un análisis in vitro, utilizando el método de difusión en disco o tambien llamado técnica de Kirby- Bauer.
Preparación de las concentraciones de los extractos
Extracto acuoso
En diferentes vasos de precipitación, se trabajó con soluciones del extracto a diferentes concentraciones (2,5 %, 5 %, 10 %), para lo cual se realizaron cálculos a partir del liofilizado de ambas especies y se lo disolvió en 3 mL de agua destilada.
Extracto hidroalcohólico
A partir del extracto hidroalcohólico obtenido, se procedió a preparar las diferentes concentraciones del extracto de acuerdo con la especie vegetal, obteniendo en Malva sylvestris las siguientes concentraciones en volumenes diferentes (0,16 mg/10µL – 0,32 mg/20µL y 0,48 mg/30µL) y en Malva pseudolavatera (0,30 mg/10µL – 0,60 mg/20µL y 0,90 mg/30µL).
Activación de los microorganismos
Se realizó la siembra de los microorganismos antes de cada análisis, a partir de una cepa pura (E. coli ATCC 25922, S. aureus ATCC 25923, K. pneumoniae ATCC 700603) de cada uno, en cajas bipetri con agar Manitol (S. aureus) y agar Sangre (E. coli y K. pneumoniae); luego se las rotuló respectivamente y fueron colocadas en la incubadora a 37 °C durante 24 h.
Preparación y suspensión del inóculo
Se seleccionaron 4 ó 5 colonias de cada microorganismo del cultivo puro obtenido en la activación de microorganismos, se transfirieron las colonias utilizando un hisopo a un tubo estéril que contenía 3 mL de solución salina estéril, y se ajustó el inóculo a una turbidez equivalente al tubo 0,5 de la escala de McFarland, el cual corresponde a 108 microorganismos viables por mL.
Siembra de microorganismos
Se sumergió un hisopo estéril en la suspensión del inóculo y el exceso de líquido fue eliminado por rotación del hisopo contra las paredes del tubo de ensayo, luego se realizó la siembra en tres o cuatro direcciones sobre toda la superficie del medio de agar Mueller Hinton, girando dicha caja en ángulos de 90°.
Extracto acuoso
Se colocaron 20 µL de cada concentración del extracto acuoso sobre discos en blanco de la marca OxoidTM de 6 mm de diámetro, como control negativo se utilizó un disco en blanco con 20 µL de agua destilada y como control positivo (referencial) un disco de Cefotaxima; realizando cinco repeticiones. Las cajas Petri fueron debidamente rotuladas e incubadas a 37 °C durante 24 horas.
Extracto hidroalcohólico
Se colocaron tres volúmenes diferentes con sus respectivas concentraciones sobre discos en blanco de la marca OxoidTM de 6 mm de diámetro; como control negativo se utilizó un disco en blanco con 20 µL de solución hidroalcohólica (50:50) y como control positivo (referencial) un disco de Cefotaxima; realizando cinco repeticiones. Las cajas Petri fueron debidamente rotuladas e incubadas a 37°C durante 24 horas.
Medición de la zona del halo de inhibición
Para la interpretación de los resultados, se midió la zona de inhibición redondeando al perímetro más cercano al disco con una regla milimetrada, manteniendo la caja sobre el contador de colonias manual de campo oscuro de Quebec marca Reichert Technologies para medir con claridad el halo de inhibición, y luego se comparó con las medidas estandarizadas del control positivo por el CLSI de cada uno de los microorganismos utilizados.
Actividad antioxidante
Actividad antioxidante por el método de FRAP (capacidad ferro- reductora).
La capacidad de reducción de los extractos hidroalcohólicos fue medida acorde al procedimiento descrito por Benzie y Strain (1996). Las determinaciones fueron de carácter espectrofotométrico, se empleó un espectrofotómetro UV- visible a una absorbancia de 593 nm.
Concentraciones de los extractos
Los extractos hidroalcohólicos de Malva sylvestris y Malva pseudolavatera al 80 % fueron a las concentraciones de 25, 50, 100, 150 y 200 μg/mL.
Preparación de la solución FRAP
Para conformar el reactivo de FRAP, se mezcló buffer acetato de sodio 300 mM (pH 3,6), 10 mM de TPTZ (2,4,6-tripiridil-s-triazina) y 20 mM de cloruro férrico (25:2,5:2,5 v:v:v).
Evaluación de la actividad antioxidante
Se tomaron 30 μL de cada dilución de los extractos (a las concentraciones de 25, 50, 100, 150 y 200 μg/mL) y se mezclaron con 900 μL de la disolución FRAP y 90 μL de agua destilada. Una vez realizada la mezcla, la reacción que ocurre mide la reducción del complejo férrico-TPTZ, en la cual el hierro férrico (Fe3+ - TPTZ) se reduce a ión ferroso a bajo pH, causando la formación de un complejo ferroso-tripiridiltriazina (Fe2+ - TPTZ) de color azul intenso con un máximo de absorción a una longitud de onda de 593 nm. El blanco consistió en 120 μL de agua y 900 μL de reactivo. Cada determinación se llevó a cabo por triplicado.
Los resultados fueron expresados como μmol equivalentes de ácido ascórbico (EAA) y como μmol equivalentes de FeSO4, a partir del cálculo interpolando la densidad óptica (D.O) de las muestras en las curvas de calibración de ambas sustancias de referencia a las concentraciones de 100, 200, 400, 500 y 800 μM. Las lecturas se realizaron por triplicado a los cuatro minutos.
Capacidad secuestradora del radical 2,2-difenil-1-picrilhidrazilo (DPPH)
Para la evaluación de la actividad antioxidante de los extactos obtenidos de Malva sylvestris y Malva pseudolavatera, se realizó mediante la técnica del radical libre DPPH (radical 2,2-difenil-1-picrilhidracilo), basado en la metodología descrita por Brand-Willians et al., se empleó un espectrofotómetro UV-visible y las determinaciones fueron medidas a 517 nm al cabo de los 30 minutos.
Concentraciones de los extractos
Los extractos hidroalcohólicos de Malva sylvestris y Malva pseudolavatera fueron al 80 % en concentraciones de 25, 50, 100, 150 y 200 µg/mL.
Preparación de la solución de DPPH
La solución de DPPH fue preparada a una concentración de 0,075mg/mL en un matraz aforado cubierto con aluminio, empleando como solvente el metanol. Esta solución se debe preparar el mismo día que se va a realizar el ensayo dado que es una solución fotosensible. La solución debe almacenarse en un frasco color ámbar y mantenerse fuera del alcance de la luz.
Preparación del control positivo y control negativo
El control positivo utilizado en el ensayo de actividad antioxidante fue el ácido ascórbico en concentraciones de 25, 50, 100, 150 y 200 µg/mL utilizando como solvente el etanol absoluto.
El control negativo o blanco consistió en una mezcla de 900 µL de DPPH Y 100 µL de etanol absoluto.
Evaluación de la actividad antioxidante
Se tomaron 10 µL de cada concentración de los extractos (25, 50, 100, 150 y 200 μg/mL) y de las sustancias de referencia a las mismas concentraciones, se mezclaron con 900 µL del reactivo DPPH (0,075 mg/mL) y 90 µL de etanol absoluto. La reacción se dejó en la oscuridad durante 30 minutos en un espectrofotómetro y posteriormente se leyeron las muestras a una longitud de onda de 517 nm. Cada determinación se llevó a cabo por triplicado.
Los resultados fueron expresados como porcentaje de inhibición del radical DPPH según la siguiente fórmula:
![]()
Donde:
Ab: Absorbancia del blanco (nm)
Am: Absorbancia de la muestra (nm)
Ensayo del ABTS•+ (ácido 2,2’-azino-bis (3-etilbenzotiazolina)-6- sulfónico)
Para la evaluación de la actividad antioxidante de los extactos obtenidos de Malva sylvestris y Malva pseudolavatera, se realizó mediante la técnica del radical libre ABTS•+ (ácido 2,2’-azino-bis (3-etilbenzotiazolina)-6-sulfónico), se empleó un espectrofotómetro UV-visible y las determinaciones fueron medidas a 734 nm al cabo de los 30 minutos.
Concentraciones de los extractos
Los extractos hidroalcohólicos al 80 % de Malva sylvestris y Malva pseudolavatera a las concentraciones de 100, 200, 300, 400 y 500 μg/mL.
Preparación de la solución ABTS•+
El ensayo fue basado en la habilidad de diferentes sustancias de secuestrar el radical catiónico ABTS•+, el cual fue preparado mezclando una solución de ABTS 7mM y persulfato de potasio 2,45 mM (1/1, v/v). La mezcla se mantuvo en la oscuridad por 16 horas para la formación del radical. La solución ABTS•+ fue diluida con etanol al 96 % hasta lograr una absorbancia de 0,700 ± 0,05 a 734nm.
Evaluación de la actividad antioxidante
Se tomaron 980 µL de la solución de ABTS•+ radicálico con 20 µL de los extractos ensayados y la sustancia de referencia (ácido ascórbico) a las concentraciones de 100, 200, 300, 400 y 500 μg/mL. Se incubó por 30 min para su posterior lectura a 734 nm en un espectrofotómetro UV- visible. Cada determinación se llevó a cabo por triplicado.
Los resultados se expresaron como porcentaje de inhibición del radical ABTS•+ según la fórmula siguiente:

RESULTADOS
Recolección de datos
A continuación, se detalla los resultados obtenidos mediante la evaluación de la actividad antibacteriana y antioxidante de los extractos de la M. sylvestris y M. pseudolavatera.
Resultados: Actividad antibacteriana
En las tablas 5, 6, 7, 8, se muestran los resultados de los dos extractos estudiados (acuoso e hidroalcohólico) para evaluar la actividad antibacteriana de Malva sylvestris y Malva pseudolavatera contra E. coli, S. aureus y K. pneumoniae.
Malva sylvestris
Extracto acuoso
En la evaluación de la actividad antibacteriana del extracto acuoso en el cual se realizó a partir de tres concentraciones (2,5 %, 5 % y 10 %) contra E. coli, S. aureus y K. pneumoniae. Se demostró que en ninguna de las tres concentraciones evaluadas frente a E. coli y S. aureus inhibió el crecimiento de los microorganismos utilizados, pero si presenta una mínima inhibición del crecimiento bacteriano de K. pneumoniae en la concentración 5 % presentando un halo de 8 mm. y en la concentración al 10 % se obtuvo un halo de 7mm. resultados que se reflejan en la tabla 7.
En cuanto los diámetros obtenidos de los halos de inhibición del control positivo utilizado en este caso fue Cefotaxima, están dentro de los patrones estándar de halo de inhibición establecidos por NCCLS, 2000.
|
Tabla 5. Valores de halo de inhibición del extracto acuoso de M. sylvestris y controles |
|||||
|
Microorganismos |
Concentraciones |
Controles |
|||
|
2,5 % |
5 % |
10 % |
C+ (CTX) |
C- |
|
|
E. coli |
- |
- |
- |
29 mm |
- |
|
- |
- |
- |
28 mm |
- |
|
|
- |
- |
- |
30 mm |
- |
|
|
- |
- |
- |
30 mm |
- |
|
|
- |
- |
- |
30 mm |
- |
|
|
Promedio |
- |
- |
- |
29 mm |
- |
|
S. aureus |
- |
- |
- |
30 mm |
- |
|
- |
- |
- |
29 mm |
- |
|
|
- |
- |
- |
30 mm |
- |
|
|
- |
- |
- |
29 mm |
- |
|
|
- |
- |
- |
30 mm |
- |
|
|
Promedio |
- |
- |
- |
29 mm |
- |
|
K. pneumoniae |
- |
- |
- |
18 mm |
- |
|
- |
7 mm |
8 mm |
17 mm |
- |
|
|
- |
- |
7 mm |
18 mm |
- |
|
|
- |
8 mm |
7 mm |
18 mm |
- |
|
|
- |
- |
- |
18 mm |
- |
|
|
Promedio |
- |
8 mm |
7 mm |
17 mm |
- |
A continuación, se presentan fotografías más representativas de los resultados obtenidos del extracto acuoso de Malva sylvestris frente a cada microorganismo.
Escherichia coli
En la figura figura 3 se puede observar los resultados de los antibiogramas obtenidos de los extractos acuosos de Malva sylvestris en las concentraciones de 2,5 – 5 y 10 %, frente a Escherichia coli, en el cual no se presenta ningún halo de inhibición, es decir que los extractos acuosos de Malva sylvestris a las tres concentraciones de estudio no presentan actividad antibacteriana contra Escherichia coli en comparación con el antibiótico de referencia.
Figura 3. Antibiogramas obtenidos de los extractos acuosos de Malva sylvestris en las concentraciones de 2,5 – 5 y 10 % frente a Escherichia coli
Staphylococcus aureus
En la figura figura 4 se reflejan los resultados obtenidos de los antibiogramas de los extractos acuosos de Malva sylvestris en las concentraciones de 2,5 – 5 y 10 %, frente a Staphylococcus aureus, en el cual se observan que no se presenta ningún algo de inhibición, es decir que los extractos acuosos de Malva sylvestris a las concentraciones de 2,5 – 5 y 10 %, no presentan actividad antibacteriana contra Staphylococcus aureus en comparación con el antibiótico de referencia.
Figura 4. Antibiogramas de los extractos acuosos de Malva sylvestris en las concentraciones de 2,5 – 5 y 10 % frente a Staphylococcus aureus
Klebsiella pneumoniae
En las fotografías figure 5 se observa los resultados obtenidos de los antibiogramas de los extractos acuosos de Malva sylvestris en las concentraciones de 2,5 – 5 y 10 % en réplicas de cinco, frente a Klebsiella pneumoniae, en la concentración de 5 % presenta halo de inhibición de 8 mm y en la concentración de 10 % presenta halo de inhibición de 7 mm, es decir que los extractos acuosos de Malva sylvestris a las concentraciones de 5 y 10 %, presentan una moderada actividad antibacteriana contra Klebsiella pneumoniae en comparación con el antibiótico de referencia.
Figura 5. Antibiogramas de los extractos acuosos de Malva sylvestris en las concentraciones de 2,5 – 5 y 10 % frente a Klebsiella pneumoniae
Extracto hidroalcohólico
Para la evaluación de la actividad antibacteriana del extracto hidroalcohólico de Malva sylvestris se determinó en tres concentraciones diferentes (0,16 mg/10µL – 0,32 mg/20µL y 0,48 mg/30µL) contra E. coli, S. aureus y K. pneumoniae. Se demostró que a la concentración de 0,16mg/10µL del extracto no presentó inhibición de crecimiento microbiano de ninguno de los microorganismos mencionados, a la concentración de 0,32mg/20µL presentó una modera actividad contra Klebsiella pneumoniae con un halo de 7 mm, y a la concentración de 0,48mg/30µL presentó una moderada actividad de inhibición contra Escherichia coli y Klebsiella pneumoniae, mostrando halos de 7 mm (ver tabla 6).
A continuación, se presentan imágenes más representativas de los resultados obtenidos del extracto hidroalcohólico de Malva sylvestris.
|
Tabla 6. Valores de halo de inhibición del extracto hidroalcohólico de M. sylvestris y controles |
|||||
|
Microorganismos |
Concentraciones |
Controles |
|||
|
0,16 mg/10µL |
0,32 mg/20µL |
0,48 mg/30µL |
C+ (CTX) |
C- |
|
|
E. coli |
- |
7 mm |
7 mm |
29 mm |
- |
|
- |
- |
- |
28 mm |
- |
|
|
- |
- |
8 mm |
30 mm |
- |
|
|
- |
- |
7 mm |
30 mm |
- |
|
|
- |
- |
7 mm |
30 mm |
- |
|
|
Promedio |
- |
- |
7 mm |
29 mm |
- |
|
S. aureus |
- |
- |
- |
30 mm |
- |
|
- |
- |
- |
29 mm |
- |
|
|
- |
- |
- |
30 mm |
- |
|
|
- |
7 mm |
- |
29 mm |
- |
|
|
- |
- |
7 mm |
30 mm |
- |
|
|
Promedio |
- |
- |
- |
29 mm |
- |
|
K. pneumoniae |
- |
7 mm |
- |
18 mm |
- |
|
- |
- |
7 mm |
17 mm |
- |
|
|
- |
7 mm |
- |
18 mm |
- |
|
|
- |
7 mm |
- |
18 mm |
- |
|
|
- |
8 mm |
7 mm |
18 mm |
- |
|
|
Promedio |
- |
7 mm |
7mm |
17 mm |
- |
Escherichia coli
En la figura 6 se reflejan los resultados obtenidos del extracto hidroalcohólico de Malva sylvestris frente a Escherichia coli, en el cual solo presenta una moderada actividad de inhibición en la concentración 0,48mg/30µL con un halo de 7 mm.

Figura 6. Resultados obtenidos del extracto hidroalcohólico de Malva sylvestris frente a Escherichia coli
Staphylococcus aureus
En la figura 7, se reflejan los resultados obtenidos del extracto hidroalcohólico de Malva sylvestris frente a Staphylococcus aureus, en el cual no presenta actividad de inhibición en ninguna concentración.
Figura 7. Resultados obtenidos del extracto hidroalcohólico de Malva sylvestris frente a Escherichia coli
Klebsiella pneumoniae
En la figura 8 se reflejan los resultados obtenidos del extracto hidroalcohólico de Malva sylvestris frente a Klebsiella pneumoniae, en el cual no presenta actividad de inhibición en la concentración 0,16mg/10µL, pero si presenta actividad moderada en las concentraciones 0,32mg/20µL y 0,48mg/30µL, mostrando halos de 7 mm.

Figura 8. Resultados obtenidos del extracto hidroalcohólico de Malva sylvestris frente a Klebsiella pneumoniae
Malva pseudolavatera
Extracto acuoso
Los resultados obtenidos por el método de Kirby-Bauer o difusión en disco, demostraron que las bacterias gram-negativas (E.coli y K. pneumoniae) y gram- positivas (S. aureus) no presentaron halos de inhibición, en ninguna de las concentraciones (2,5 %, 5 %, 10 %) de los extractos acuosos analizados. Se consideró como control positivo cefotaxima y como control negativo el agua destilada. Los resultados obtenidos se muestran en la tabla 7.
|
Tabla 7. Valores de halo de inhibición del extracto acuoso de M. pseudolavatera y controles |
|||||
|
Microorganismos |
Concentraciones |
Controles |
|||
|
2,5 % |
5 % |
10 % |
C+ (CTX) |
C- |
|
|
E. coli |
- |
- |
- |
30 mm |
- |
|
- |
- |
- |
29 mm |
- |
|
|
- |
- |
- |
30 mm |
- |
|
|
- |
- |
- |
30 mm |
- |
|
|
- |
- |
- |
30 mm |
- |
|
|
Promedio |
- |
- |
- |
29,8 mm |
- |
|
S. aureus |
- |
- |
- |
30 mm |
- |
|
- |
- |
- |
28 mm |
- |
|
|
- |
- |
- |
29 mm |
- |
|
|
- |
- |
- |
30 mm |
- |
|
|
- |
- |
- |
28 mm |
- |
|
|
Promedio |
- |
- |
- |
29 mm |
- |
|
K. pneumoniae |
- |
- |
- |
18 mm |
- |
|
- |
- |
- |
17 mm |
- |
|
|
- |
- |
- |
18 mm |
- |
|
|
- |
- |
- |
18 mm |
- |
|
|
- |
- |
- |
18 mm |
- |
|
|
Promedio |
- |
- |
- |
17,8 mm |
- |
A continuación, se presentan imágenes más representativas de los resultados obtenidos del extracto acuoso de Malva pseudolavatera.
Escherichia coli
De acuerdo a los resultados obtenidos, en el antibiograma realizado con el extracto acuoso de Malva pseudolavatera frente a la cepa de E.coli se puede apreciar que no hubo halos de inhibición en ninguna de las concentraciones evaluadas (ver figura 9); mientras que con el antibiótico (cefotaxima) utilizado como control positivo frente a la misma cepa, se pueden observar los respectivos halos de inhibición (ver figura 9.34).
Figura 9. Antibiograma realizado con el extracto acuoso de Malva pseudolavatera frente a la cepa de E.coli
Staphylococcus aureus
De acuerdo con los resultados obtenidos, en el antibiograma realizado con el extracto acuoso de Malva pseudolavatera frente a la cepa de S. aureus se puede apreciar que no hubo halos de inhibición en ninguna de las concentraciones evaluadas (ver figura 10); mientras que con el antibiótico (cefotaxima) utilizado como control positivo frente a la misma cepa, se pueden observar los respectivos halos de inhibición (Ver figura 10.38).

Figura 10. Antibiograma realizado con el extracto acuoso de Malva pseudolavatera frente a la cepa de E.coli
Klebsiella pneumoniae
De acuerdo con los resultados obtenidos, en el antibiograma realizado con el extracto acuoso de Malva pseudolavatera frente a la cepa de K. pneumoniae se puede apreciar que no hubo halos de inhibición en ninguna de las concentraciones evaluadas (ver figura 11); mientras que con el antibiótico (cefotaxima) utilizado como control positivo frente a la misma cepa, se pueden observar los respectivos halos de inhibición (ver figura 11.42).
Figura 11. Antibiograma realizado con el extracto acuoso de Malva pseudolavatera frente a la cepa de K. pneumoniae
Extracto hidroalcohólico
Los resultados obtenidos por el método de Kirby-Bauer o difusión en disco, a partir del extracto hidroalcohólico con una concentración de 150,7mg/5 mL de Malva pseudolavatera, demostraron que a los diferentes volúmenes con sus respectivas concentraciones (0,30mg/10µL, 0,60mg/20µL, 0,90mg/30µL), los microorganismos gram-negativos (E. coli y K. pneumoniae) no presentaron halos de inhibición. Por otro lado, el microorganismo gram-positivo (S. aureus) no presentó halos de inhibición en las concentraciones 0,30mg/10µ y 0,60mg/20µL; mientras que en la concentración de 0,90mg/30 µL presentó halos de inhibición de 7 mm y 8 mm de diámetro. Se consideró como control positivo la cefotaxima y como control negativo la solución hidroalcohólica (50:50). Los resultados obtenidos se muestran en la tabla 10.
|
Tabla 8. Valores de halo de inhibición del extracto hidroalcohólico de M. pseudolavatera y controles |
|||||
|
Microorganismos |
Concentraciones |
Controles |
|||
|
0,30 mg/10µL |
0,60 mg/20µL |
0,90 mg/30µL |
C+ (CTX) |
C- |
|
|
E. coli |
- |
- |
- |
30 mm |
- |
|
- |
- |
- |
29 mm |
- |
|
|
- |
- |
- |
30 mm |
- |
|
|
- |
- |
- |
30 mm |
- |
|
|
- |
- |
- |
30 mm |
- |
|
|
Promedio |
- |
- |
- |
29,8 mm |
- |
|
S. aureus |
- |
- |
7 mm |
28 mm |
- |
|
- |
- |
7 mm |
27 mm |
- |
|
|
- |
- |
8 mm |
29 mm |
- |
|
|
- |
- |
8 mm |
28 mm |
- |
|
|
- |
- |
7 mm |
28 mm |
- |
|
|
Promedio |
- |
- |
7,4 mm |
28 mm |
- |
|
K. pneumoniae |
- |
- |
- |
18 mm |
- |
|
- |
- |
- |
17 mm |
- |
|
|
- |
- |
- |
18 mm |
- |
|
|
- |
- |
- |
18 mm |
- |
|
|
- |
- |
- |
18 mm |
- |
|
|
Promedio |
- |
- |
- |
17,8 mm |
- |
A continuación, se presentan imágenes más representativas de los resultados obtenidos del extracto hidroalcohólico de Malva pseudolavatera.
Escherichia coli
De acuerdo a los resultados obtenidos, en el antibiograma realizado con el extracto hidroalcohólico de Malva pseudolavatera frente a la cepa de E.coli se puede apreciar que no hubo halos de inhibición en ninguna de las concentraciones evaluadas, ni con la solución hidroalcohólica (50:50) utilizada como control negativo (ver figuras 12); mientras que con el antibiótico (cefotaxima) utilizado como control positivo frente a la misma cepa, se pueden observar los respectivos halos de inhibición (ver figura 12.47).

Figura 12. Antibiograma realizado con el extracto hidroalcohólico de Malva pseudolavatera frente a la cepa de E.coli
Staphylococcus aureus
De acuerdo a los resultados obtenidos, en el antibiograma realizado con el extracto hidroalcohólico de Malva pseudolavatera frente a la cepa de S. aureus se puede apreciar que no hubo halos de inhibición en las concentraciones 0,30mg/10µL, 0,60mg/20µL, ni con la solución hidroalcohólica (50:50) utilizada como control negativo (ver figura 13); mientras que a una concentración de 0,90mg/30µL se apreciaron halos de 7 mm y 8 mm de diámetro (ver figura 13.50) y con el antibiótico (cefotaxima) utilizado como control positivo frente a la misma cepa, se pueden observar los respectivos halos de inhibición (Ver figura 13.51).

Figura 13. Antibiograma realizado con el extracto hidroalcohólico de Malva pseudolavatera frente a la cepa de S. aureus
Klebsiella pneumoniae

Figura 14. Antibiograma realizado con el extracto hidroalcohólico de Malva pseudolavatera frente a la cepa de K. pneumoniae
Resultados: Actividad antioxidante
Método de FRAP (capacidad ferroreductora)
El ensayo FRAP está basado en la habilidad de los compuestos fenólicos para reducir Fe3+ a Fe2+. En presencia de 2,4,6-tripiridil-s-triazina, la reducción se encuentra acompañada de la formación de un complejo coloreado de Fe2+ de color azul. El extracto a las cinco concentraciones ensayadas mostró desde el punto de vista cualitativo un cambio del color a azul intenso, lo cual es indicativo de la presencia de sustancias antioxidantes en el mismo.
Los resultados expresaron la capacidad reductora del catión Fe3+ del extracto como μM equivalentes de ácido ascórbico y μM equivalentes de FeSO4 (sustancias de referencias utilizadas y reconocidas por tener un alto valor antioxidante), a partir de las curvas de calibración de dichos patrones obtenidas por regresión lineal (figura 15) con sus respectivas ecuaciones, donde Y es la absorbancia y X la concentración.

Figura 15. Curvas de calibración del ácido ascórbico y el FeSO4 para la determinación de la capacidad antioxidante por FRAP
Se logró una buena correlación entre las concentraciones ensayadas de las sustancias de referencia y las densidades ópticas, con un coeficiente de correlación cercano a 0,99; esto es indicativo del buen ajuste de la ecuación del modelo a los datos experimentales.
En la tabla 9 se muestra la actividad ferro-reductora asociada a los extractos evaluados. Se evidenció actividad antioxidante de manera concentración- dependiente, lográndose en todas las concentraciones ensayadas de los extractos, valores superiores (en equivalentes de ácido ascórbico y FeSO4) a la menor concentración ensayada (100 μM) de cada sustancia de referencia.
|
Tabla 9. Actividad ferro-reductora de los extractos hidroalcohólicos de Malva sylvestris y Malva pseudolavatera |
||||
|
Concentración μg/mL |
Actividad ferro-reductora ± DE |
|||
|
μM equivalentes de ácido ascórbico |
μM equivalentes de FeSO4 |
|||
|
Malva silvestre |
Malva Pseudolavatera |
Malva silvestre |
Malva Pseudolavatera |
|
|
25 |
348,67/5,47a |
341,43/4,35a |
112,88/5,13i |
106,08/4,08i |
|
50 |
416,06/9,04b |
387,08/9,96c |
176,14/8,49j |
148,93/9,35k |
|
100 |
521,14/15,42d |
487,08/11,29e |
280,42/6,35l |
242,81/10,60m |
|
150 |
651,57/14,14f |
635,63/14,79f |
397,23/13,27n |
382,26/13,88n |
|
200 |
832,73/19,31g |
745,05/7,63h |
567,30/18,14o |
484,99/7,16p |
|
Nota: se indica la media (n=3) ± desviación estándar (DE). Letras diferentes en un mismo μM equivalente para los dos extractos a la misma concentración indica diferencias significativas y letras iguales que no existen diferencias significativas (p≤ 0,05), según t-student |
||||
Los resultados permitieron sugerir que el extracto hidroalcohólico de Malva silvestre presenta mayor actividad ferro-reductora que el extracto de Malva pseudolavatera, lo cual se traduce en los altos valores de μM equivalentes expresados en función de las sustancias de referencias ensayadas.
Capacidad secuestradora del radical 2,2-difenil-1-picrilhidrazilo (DPPH)
Desde el punto de vista cualitativo se pudo apreciar un cambio de coloración de púrpura a amarillo en ambos extractos conforme iba aumentando la concentración. Esto se debe por la presencia de sustancias antioxidantes en el extracto que redujeron el radical 2,2-difenil-1-picrihidracilo (DPPH) en conjunto, con la pérdida de absorbancia en la disolución.
Se presentaron diferencias significativas entre las muestras en la mayoría de las concentraciones ensayadas. A la concentración de 100 μg/mL, los dos extractos no manifestaron diferencias significativas en los porcentajes de secuestro del radical, con valores superiores al 55 %, aunque menor que las sustancias de referencias. Pero también fue posible observar una buena actividad antioxidante de los dos extractos, ya que a mayor concentración de los extractos hidroalcohólicos de ambas especies se obtuvieron valores superiores al 75 %. Los resultados obtenidos se encuentran en la tabla 10.
|
Tabla 10. Capacidad secuestradora del radical DPPH de los extractos hidroalcohólicos de M. sylvestris, M. pseudolavatera y las sustancias de referencias |
||||
|
Concentración μg/mL |
Porciento de secuestro del radical DPPH (%) ± DE |
|||
|
Malva sylvestris |
Malva pseudolavatera |
Vitamina C |
Trolox |
|
|
25 |
39,53/1,05a |
37,88/0,70b |
69,46/0,86c |
76,62/0,60d |
|
50 |
51,10/0,90e |
48,19/0,75f |
78,47/0,76g |
80,07/0,38h |
|
100 |
61,81/1,80i |
59,95/0,92i |
82,23/0,43j |
83,03/0,83j |
|
150 |
67,66/0,82k |
65,76/1,33l |
83,73/0,70m |
83,98/0,62m |
|
200 |
77,82/0,67n |
75,22/0,51o |
85,68/0,37p |
85,73/0,68p |
|
Nota: se indica la media (n=3) ± desviación estándar (DE). Letras diferentes en una fila indica diferencias significativas y letras iguales que no existen diferencias significativas, a una misma concentración (p≤ 0,05), según el test de comparación múltiple de Tukey |
||||
A continuación, se muestra en la figura 16, el comportamiento de la capacidad secuestradora del radical DPPH de los extractos hidroalcohólicos de Malva sylvestris, Malva pseudolavatera y las sustancias de referencias, en donde se puede observar que existe una tendencia al aumento de la capacidad de inhibición de dicho radical a medida que aumenta la concentración.

Figura 16. Comportamiento de la capacidad secuestradora del radical DPPH
Ensayo del ABTS●+ (ácido 2,2’-azino-bis (3-etilbenzotiazolina)-6- sulfónico)
Durante el desarrollo de este método, se observó una decoloración del radical catiónico ABTS•+ a todas las concentraciones evaluadas, debido a la capacidad del extracto y las sustancias de referencia de neutralizar dicho radical, esto se ve reflejado en un descenso de absorbancia y una disminución del color azul- verde intenso hasta su decoloración.
En la tabla 13 se presentan los porcentajes de inhibición del radical ABTS•+ y se apreciaron diferencias significativas entre las muestras ensayadas. Los extractos evidenciaron a la mínima concentración (100 μg/mL) una capacidad de secuestro superior al 50 %, incluso superior, a las mismas concentraciones evaluadas para las dos sustancias de referencia. A las concentraciones de 200 y 300 μg/mL los extractos exhibieron mayor porcentaje de inhibición que el Trolox, lo que sugiere una elevada actividad antioxidante.
|
Tabla 11. Capacidad secuestradora del radical ABTS●+ de los extractos hidroalcohólicos de Malva sylvestris, Malva pseudolavatera y las sustancias de referencias |
||||
|
Concentración μg/mL |
Porciento de secuestro del radical ABTS●+ (%) ± DE |
|||
|
Malva sylvestris |
Malva pseudolavatera |
Vitamina C |
Trolox |
|
|
100 |
52,78/0,44a |
50,63/0,72b |
44,22/0,66c |
37,72/0,73d |
|
200 |
61,87/0,44e |
59,67/0,81f |
71,45/0,73g |
50,87/0,81h |
|
300 |
68,51/0,66i |
66,17/0,30j |
81,86/0,69k |
61,43/0,77l |
|
400 |
79,12/0,37m |
77,75/0,34n |
90,95/0,83o |
84,20/0,66p |
|
500 |
85,83/0,45q |
85,13/0,33q |
92,56/0,30r |
89,43/0,50s |
|
Nota: se indica la media (n=3) ± desviación estándar (DE). Letras diferentes en una fila indica diferencias significativas y letras iguales que no existen diferencias significativas, a una misma concentración (p≤ 0,05), según el test de comparación múltiple de Tukey |
||||
DISCUSIÓN
Actividad antibacteriana
En estudio in vitro para evaluar la actividad antibacteriana de extractos hidroalcohólicos obtenidos por maceración de diferentes plantas, uno de ellos fue proveniente de Malva sylvestris, para brindar una alternativa en el tratamiento de la periodontitis.(41,42) Todos los extractos tuvieron actividad antibacteriana frente al microorganismo estudiado, Aggregatibacter actinomycetemcomitans, sus halos de inhibición fueron comparados con la clorhexidina al 0,2 % con el protocolo establecido en el CLSI. La actividad antibacteriana más baja (de las 3 plantas estudiadas) fue de Malva sylvestris.(43,44)
En un estudio se realizó la bioactividad de Malva sylvestris frente a diferentes patógenos, en donde utilizaron sus hojas y flores para realizar los respectivos extractos (n-hexano, diclorometano y metanol). Sus resultados revelaron que posee actividad antibacteriana en el extracto metanólico frente al Staphylococcus aureus, Erwinia carotovora, Streptococcus agalactiae y Enterococcus faecalis, además posee una actividad citotóxica elevada, razón por la cual puede ser usada como un agente antiproliferativo. Finalmente, concluyeron que esta planta puede ser usada como agente antiséptico para eliminar patógenos resistentes a antibióticos.(45)
En un estudio la actividad antibacteriana de diferentes extractos (metanólicos y diclorometánicos) de distintas plantas frente al Staphylococcus aureus, dentro de este grupo se encontraba el género Malva (parviflora). Para el ensayo de la actividad antibacteriana se sometió la cepa del S. aureus a una concentración de 10 mg/mL de cada uno de los extractos, dando como resultado para el género de Malva en ambos extractos una actividad inhibitoria escasa.(46,47)
Según el Dr. Jorge Alonso en el Taller de Plantas Medicinales y Atención Primaria de la Salud, llamado “Técnicas de comprobación de actividad terapéutica en plantas medicinales” detalla lo siguiente: Si en los resultados obtenidos, hay halos de inhibición >9 mm es positivo (con actividad), entre 6-9 mm es intermedio (actividad moderada), y <6 mm es negativo (sin actividad), estos valores solo se aplican para extractos vegetales.(48)
De acuerdo con lo anteriormente mencionado, este género tuvo un comportamiento similar con los distintos microorganismos evaluados en este estudio, ya que en la evaluación de la actividad antibacteriana en el extracto acuoso con diferentes concentraciones (2,5 %, 5 %, 10 %) de Malva sylvestris, se pudo observar que con las cepas de E. coli y S. aureus no presentó actividad, pero se pudo apreciar una moderada actividad frente a la cepa de K. pneumoniae a concentraciones de 5 % y 10 %.(49) En cuanto al extracto hidroalcohólico con concentraciones en base a los volúmenes evaluados, se pudo observar que a una concentración de 0,16 mg/10 µL no presentó actividad frente a las cepas de los microorganismos evaluados, pero a concentraciones de 0,32 mg/20 µL y 0,48mg/30 µL si presentó una moderada actividad frente a las bacterias Gram- negativas.(50)
Por otro lado, los extractos acuosos de Malva pseudolavatera con diferentes concentraciones (2,5 %, 5 %, 10 %) frente a las cepas de E. coli, S. aureus y K. pneumoniae no presentaron actividad. En cuanto al extracto hidroalcohólico con concentraciones en base a los volúmenes evaluados, se pudo observar que a las concentraciones de 0,30mg/10 µL y 0,60 mg/20 µL no presentaron actividad frente a ninguna de las cepas de los microorganismos mencionados, pero a la concentración de 0,90 mg/30 µl se pudo apreciar una actividad moderada contra la bacteria Gram-positiva.(51)
Actividad antioxidante
En un estudio se realizó una cuantificación de fenoles y flavonoides totales en extractos (metanólicos) naturales de Malva sylvestris y otras plantas. En donde dio como resultado una cantidad significativa de compuestos fenólicos los cuales están relacionados con propiedades farmacológicas, como, por ejemplo, reducir el riesgo de padecer enfermedades crónico-degenerativas.(52,53,54)
En un estudio se realizó la extracción de polisacáridos de las hojas de Malva sylvestris y evaluaron su actividad antioxidante; dando como resultado fuertes actividades de captación in vitro en DPPH y radicales hidroxilos, razón por la cual concluyeron que pueden tener aplicaciones potenciales en las industrias médicas y alimenticias.(55,56,57)
En un estudio se evaluó la actividad cualitativa y cuantitativa de los pigmentos vegetales (antioxidantes) de Malva sylvestris y Malva moschata. Se elaboraron extractos de acetona. El análisis cualitativo se realizó por cromatografía de papel y el análisis cuantitativo mediante espectrofotometría.(58,59) Según los resultados, ambas plantas poseen cantidad significativa de pigmentos vegetales (Clorofila A, Clorofila B y Carotenoides) que pueden desempeñar un papel importante como antioxidantes y como medios anticancerígenos; sin embargo, la especie moschata es más eficaz como antioxidante que la especie sylvestris.(60,61)
De acuerdo a lo anteriormente mencionado, cabe indicar que la evaluación de la actividad antioxidante de los extractos hidroalcohólicos de Malva sylvestris y Malva pseudolavatera evaluados, mantuvieron un comportamiento similar en este estudio, ya que según los resultados de los tres métodos in vitro realizados, se pudo comprobar que a medida que aumentaba la concentración de los extractos ensayados, la capacidad reductora incrementaba (FRAP) y la actividad antirradicalaria (DPPH y ABTS•+) también, manifestándose de esta manera, una elevada actividad antioxidante.(62,63)
CONCLUSIONES
Los extractos acuosos de las especies de Malva sylvestris y Malva pseudolavatera, solo presentó moderada actividad antibacteriana la especie Malva sylvestris y los extractos hidroalcohólicos de Malva sylvestris presentaron moderada actividad sobre Escherichia coli y Klebsiella pneumoniae, finalmente los extractos hidroalcohólicos de Malva pseudolavatera presentaron moderada inhibición frente a Staphylococcus aureus.
De los resultados obtenidos en cuanto la evaluación in vitro de los extractos acuosos e hidroalcohólicos sobre los microorganismos se pudo definir que solo presentó actividad los extractos acuosos de Malva sylvestris a la concentración de 10 % que presentó un halo de inhibición de 8 mm frente a Klebsiella pneumoniae. Por otra parte, los extractos hidroalcohólicos de M. sylvestris a las concentraciones (0,16mg/10µL – 0,32mg/20µL y 0,48mg/30µL) presentó moderada inhibición la concentración 0,48mg/30µL con un halo de 7 mm frente a
E. coli y K. pneumoniae y los extractos hidroalcohólicos de M. pseudolavatera (0,30 mg/10µL – 0,60 mg/20µL y 0,90 mg/30uL), se observó que presentaron moderada inhibición a la concentración de 0,90 mg/30µL frente a S. aureus, según lo indica el Dr. Jorge Alonso en el taller de plantas medicinales “técnicas de comprobación de acción terapéutica”.
La actividad antioxidante de los extractos hidroalcohólicos fue evaluada por tres métodos que presentan múltiples mecanismos, los métodos DPPH y ATBS se basan en la eliminación de ciertos radicales y el método FRAP mide el potencial de actividad de reducción férrica, teniendo en consideración los resultados de los tres métodos in vitro ensayados se pudo constatar que a medida que aumentaba la concentración de los extractos, aumentaba el poder reductor (ensayo FRAP) y la actividad antirradicalaria (ensayos DPPH y ATBS, manifestando una elevada actividad antioxidante.
RECOMENDACIONES
Evaluar la actividad antibacteriana de Malva sylvestris y Malva pseudolavatera, utilizando diferentes microorganismos y empleando otro solvente para la obtención de sus extractos. Realizar nuevos ensayos sobre la actividad antibacteriana y antioxidante, utilizando como muestra otros órganos de la planta Malva sylvestris y Malva pseudolavatera.
REFERENCIAS BIBLIOGRÁFICAS
1. Alonso J. Técnicas de comprobación de actividad terapéutica de las plantas medicinales [Internet]. 2002 [citado el 12 Oct 2023]. Disponible en: http://www.sld.cu/galerias/pdf/sitios/mednat/comprobacion_de_la_actividad_terapeutica_de_las_plantas.pdf
2. Andrade V, Silva J. Caracterización de Klebsiella pneumoniae productora de la β-lactamasa SHV-5 en una unidad de cuidados intensivos. Salud Publica Mex. 2004;46(6):524-8.
3. Avello M, Suwalsky M. Radicales libres, antioxidantes naturales y mecanismos de protección. Atenea. 2006;2(494):161-72.
4. Barros L, Carvalho AM, Ferreira IC. Leaves, flowers, immature fruits and leafy flowered stems of Malva sylvestris: a comparative study of the nutraceutical potential and composition. Food Chem Toxicol. 2010;48(6):1466-72.
5. Basualdo J, Coto C, Torres R. Antibióticos y antimicrobianos [Internet]. Agrovet Market Animal Health; 2007 [citado el 12 Oct 2023]. Disponible en: https://www.agrovetmarket.com/investigacion-salud-animal/pdf-download/antibioticos-y-antimicrobianos
6. Bautista L. Contribución al estudio de flavonoides en hojas y determinación de la actividad antioxidante en Chromolaena tacotana [Internet]. Universidad de Ciencias Aplicadas y Ambientales (U.D.C.A); 2017 [citado el 12 Oct 2023]. Disponible en: https://repository.udca.edu.co/bitstream/11158/720/1/tesis%20C.tacotana%2031-08-2017.pdf
7. Bush LM. Infecciones por Staphylococcus aureus [Internet]. Manual MSD; 2015 [citado el 12 Oct 2023]. Disponible en: https://www.msdmanuals.com/es-ec/hogar/infecciones/infecciones-bacterianas/infecciones-por-staphylococcus-aureus#v784042_es
8. Cervantes E, García R, Salazar P. Características generales del Staphylococcus aureus. Rev Latinoam Patol Clin Med Lab. 2014;61(1):28-40.
9. Cheng C, Wang Z. Bacteriostasic activity of anthocyanin of Malva sylvestris. J For Res. 2006;17(1):83-5.
10. CLSI. Instituto de Estándares Clínicos y de Laboratorio [Internet]. 2019 [citado el 12 Oct 2023]. Disponible en: https://clsi.org/about/about-clsi/
11. Cogo LL, Monteiro CL, Miguel MD, Miguel OG, Cunico MM, Ribeiro ML. Anti-Helicobacter pylori activity of plant extracts traditionally used for the treatment of gastrointestinal disorders. Braz J Microbiol. 2010;41(2):304-9.
12. Coronado M, Vega S, Vasquéz M. Antioxidantes: perspectiva actual para la salud humana. Rev Chil Nutr. 2015;42(2):206-12.
13. Corrales LC, Muñoz MM. Estrés oxidativo: origen, evolución y consecuencias de la toxicidad del oxígeno. Rev Cienc Bioméd. 2012;10(18):135-50.
14. DellaGreca A, Cutillo F, Abrosca B, Fiorentino A, Zarrelli A. Antioxidant and radical scavenging properties of Malva sylvestris. Nat Prod Commun. 2009;4:893-6.
15. Dipak P. A review on biological activities of common mallow (Malva sylvestris L.). Innovare J Life Sci. 2016;4(5):1-5.
16. Dolatkhahi M, Dolatkhahi A, Nejad J. Ethnobotanical study of medicinal plants used in Arjan-Parishan protected area in Fars Province of Iran. Avicenna J Phytomed. 2014;4(6):402-12.
17. Dulger B, Gonuz A. Antimicrobial activity of some Turkish medicinal plants. Pak J Biol Sci. 2004;7(9):1559-62.
18. Echeverri LM, Cataño JC. Klebsiella pneumoniae como patógeno intrahospitalario: epidemiología y resistencia. Iatreia. 2010;23(3):240-9.
19. Elsagh M, Fartookzade MR, Kamalinejad M, Anushiravani M, Feizi A, Behbahani FA, et al. Efficacy of the Malva sylvestris L. flowers aqueous extract for functional constipation: a placebo-controlled trial. Complement Ther Clin Pract. 2015;21(2):105-11.
20. Esparza MJ. Descripción general de los principales grupos de fármacos antimicrobianos. Antibióticos [Internet]. 2008 [citado el 12 Oct 2023]. Disponible en: https://guia-abe.es/generalidades-descripcion-general-de-los-principales-grupos-de-farmacos-antimicrobianos-antibioticos-
21. Faner R, Sibila O, Agustí A, Bernasconi E, Chalmers J, Huffnagle G, et al. The microbiome in respiratory medicine: current challenges and future perspectives. Eur Respir. 2017;49(4):1-12.
22. Gallegos M. Las plantas medicinales: principal alternativa para el cuidado de la salud, en la población rural de Babahoyo, Ecuador. An Fac Med. 2016;77(4):327-32.
23. Gasparetto JC, Ferreira CA, Hayashi SS, Otuky MF, Pontarolo R. Ethnobotanical and scientific aspects of Malva sylvestris L.: a millennial herbal medicine. J Pharm Pharmacol. 2011;64:172-89.
24. Gerra E. Estrés oxidativo, enfermedades y tratamientos antioxidantes. An Med Interna. 2001;18(6):50-9.
25. Gracia MA. Cuantificación de fenoles y flavonoides totales en extractos naturales [Internet]. Querétaro: Universidad Autónoma de Querétaro; 2007 [citado el 12 Oct 2023]. Disponible en: https://www.uaq.mx/investigacion/difusion/veranos/memorias-2007/56_1UAQGarciaNava.pdf
26. Jaradet NA, Abualhasan MN, Ali LA. Comparison of anti-oxidant activities and exhaustive extraction yields between wild and cultivated Cyclamen persicum, Malva sylvestris, and Urtica pilulifera leaves. J Appl Pharm Sci. 2015;5(4):101-6.
27. Lespada M, Córdova E, Roca V, Gómez N. Bacteriemia por Klebsiella pneumoniae productora de carbapenemasa tipo KPC: estudio comparativo y evolución en 7 años. Rev Soc Esp Quimioter. 2019;32(1):15-21.
28. López JA, Echeverri LM. K. pneumoniae: ¿la nueva ‘’superbacteria’’? Patogenicidad, epidemiología y mecanismos de resistencia. Iatreia. 2010;23(2):157-65.
29. Loza EH. Uso de antibióticos en infecciones de piel y partes blandas en niños de 1 a 5 años internados en el servicio de Infectología del Hospital Pediátrico Baca Ortiz, de la ciudad de Quito, periodo de agosto 2015 a agosto 2016 [tesis en Internet]. Quito: Universidad Central del Ecuador; 2017 [citado el 12 Oct 2023]. Disponible en: http://www.dspace.uce.edu.ec:8080/bitstream/25000/11199/1/T-UCE-0006-020-2017.pdf
30. Macías ET. Extracción y cuantificación de compuestos fenólicos en cáscara de rambután (Nephelium lappaceum L.) de dos variedades (dulce y amarga) [tesis en Internet]. Guayaquil: Universidad de Guayaquil; 2019 [citado el 12 Oct 2023]. Disponible en: http://repositorio.ug.edu.ec/bitstream/redug/39960/1/BCIEQ-T-0372%20Mac%C3%ADas%20Torres%20Evelyn%20Tiffany.pdf
31. Macri M, Kaler M. Guía de medicamentos esenciales para el PNA antimicrobianos [Internet]. Ministerio de Salud Presidencia de la Nación; 2017 [citado el 12 Oct 2023]. Disponible en: http://www.msal.gob.ar/images/stories/bes/graficos/0000001087cnt-medicamentos-esenciales-primer-nivel-atencion-antimicrobianos.pdf
32. Malik SN, Mohammed HJ, Misak JA. Screening of antibacterial properties for some Iraqi plants against Salmonella typhimurium. Iraqui J Vet Med. 2011;35(2):28-35.
33. Mercado G, De la Rosa L. Compuestos polifenólicos y capacidad antioxidante de especias típicas consumidas en México. Nutr Hosp. 2013;1-11.
34. Mesa A, Zapata S, Arana L. Actividad antioxidante de extractos de diferente polaridad de Ageratum conyzoides L. Bol Latinoam Caribe Plantas Med Aromat. 2015;14(1):1-10.
35. Molina J, Eslava CA. Escherichia coli diarrogénica [Internet]. Departamento de Salud Pública, Facultad de Medicina, UNAM; 2015 [citado el 12 Oct 2023]. Disponible en: http://www.facmed.unam.mx/deptos/microbiologia/bacteriologia/escherichia-coli.html
36. Mosquito S, Ruiz J, Bauer JL, Ochoa TJ. Mecanismo moleculares de resistencia antibiótica en Escherichia coli asociadas a diarrea. Rev Peru Med Exp Salud Publica. 2011;28(4):648-56.
37. Organización Mundial de la Salud (OMS). 10 datos sobre la resistencia a los antimicrobianos [Internet]. OMS; 2017 [citado el 12 Oct 2023]. Disponible en: http://www.who.int/features/factfiles/antimicrobial_resistance/es/
38. Organización Mundial de la Salud (OMS). Las 10 principales causas de defunción [Internet]. OMS; 2018 [citado el 12 Oct 2023]. Disponible en: http://www.who.int/es/news-room/fact-sheets/detail/the-top-10-causes-of-death
39. Ouldyeroukarima RS, Belhocine A, Mekness A, Meddah B, Tirtouil A. Phytochemical and antioxidant study of Malva sylvestris from the west of Algeria. Glob Adv Res J Microbiol. 2017;6(5):30-2.
40. Peñarrieta M, Tejeda L, Mollinedo P. Compuestos fenólicos y su presencia en alimentos. Rev Boliv Quim. 2014;31(2):68-81.
41. Picazo JJ. Métodos básicos para el estudio de sensibilidad a los antimicrobianos [Internet]. Sociedad Española de Enfermedades Infecciosas y Microbiología Clínica; 2000 [citado el 12 Oct 2023]. Disponible en:https://www.seimc.org/contenidos/documentoscientificos/procedimientosmicrobiologia/seimc-procedimientomicrobiologia11.pdf
42. Quizhpe A, Murray M, Muñoz G, Peralta J, Calle K. Recuperar la salud integral y la armonía de los ecosistemas, para contener la resistencia bacteriana a los antibióticos [Internet]. React Latinoamérica; 2011 [citado el 12 Oct 2023].
43. Ramírez R, Mojica D, Espitia M. Actividad antibacteriana de extractos de plantas provenientes del área rural de Soracá contra Staphylococcus aureus resistente a meticilina (SARM). Rev Cienc Salud. 2015;7(1):4-12.
44. Razavi S, Zarrini G, Molavi G, Ghasemi G. Bioactivity of Malva sylvestris L., a medicinal plant from Iran. J Basic Med Sci. 2011;14(6):574-9.
45. Redzic S, Hodzic N, Tuka M. Pigmentos vegetales (antioxidantes) de plantas medicinales Malva sylvestris L. y Malva moschata L. (Malvaceae). Bosn J Basic Med Sci. 2005;5(2):53-8.
46. Rodríguez G. Principales características y diagnóstico de los grupos patógenos de Escherichia coli. Salud Publica Mex. 2002;44(5):465-75.
47. Rojo V, Vázquez P, Reyes LP, Cervero M. Factores de riesgo y evolución clínica de las infecciones causadas por Klebsiella pneumoniae productora de carbapenemasas en un hospital universitario de España: estudio de casos y controles. Rev Esp Quimioter. 2018;31(5):427-34.
48. Samatavi V, Manoochehrizade A. Polisacárido extracción de Malva sylvestris y su actividad antioxidante. Int J Biol Macromol. 2013;60:427-36.
49. Santamaría EJ. Comprobación del efecto cicatrizante de los extractos hidroalcohólicos de Malva sylvestris L. y aguacate (Persea americana) en ratones (Mus musculus) [Internet]. Escuela Superior Politécnica de Chimborazo; 2013 [citado el 12 Oct 2023]. Disponible en: http://dspace.espoch.edu.ec/bitstream/123456789/3231/1/56T00411.pdf
50. Seija V, Vignoli R. Principales grupos de antibióticos [Internet]. Bacteriología y virología médica; 2016 [citado el 12 Oct 2023]. Disponible en: http://www.higiene.edu.uy/cefa/2008/BacteCEFA34.pdf
51. Terrain. Malva pseudolavatera (Small tree mallow) [Internet]. Taranaki Educational Resource Research Analysis and Information Network; 2018 [citado el 12 Oct 2023]. Disponible en: http://www.terrain.net.nz/friends-of-te-henui-group/weeds-by-scientific-names/mallow-malva-linnaei-cretan-mallow.html
52. Tortora G, Funke B, Case C. El mundo microbiano y usted. En: Tortora G, Funke B, Case C, editores. Introducción a la microbiología. Buenos Aires: Editorial Médica Panamericana; 2015. p. 2-24.
53. Vahabi S, Hakemi-Vala M, Gholami S. In vitro antibacterial effect of hydroalcoholic extract of Lawsonia inermis, Malva sylvestris, and Boswellia serrata on Aggregatibacter actinomycetemcomitans. Adv Biomed Res. 2019;8(1):8-22.
54. Venereo J. Daño oxidativo, radicales libres y antioxidantes. Rev Cubana Med Mil. 2002;31(2):126-33.
55. Walter C, Shinwari Z, Afzal I, Malik R. Antibacterial activity in herbal products used in Pakistan. Pak J Bot. 2011;43:155-62.
56. World Health Organization (WHO). Antimicrobial resistance: global report on surveillance [Internet]. Geneva: WHO; 2014 [citado el 12 Oct 2023]. Disponible en: http://apps.who.int/iris/bitstream/handle/10665/112642/9789241564748_eng.pdf?sequence=1
57. World Health Organization (WHO). Escherichia coli [Internet]. Geneva: WHO; 2018 [citado el 12 Oct 2023]. Disponible en: https://www.who.int/topics/escherichia_coli_infections/es/
58. World Health Organization (WHO). Resistencia a los antibióticos [Internet]. Geneva: WHO; 2018 [citado el 12 Oct 2023]. Disponible en: https://www.who.int/es/news-room/fact-sheets/detail/resistencia-a-los-antibióticos
59. Zambrano L, Buenaño M, Mancera N, Jiménez E. Estudio etnobotánico de plantas medicinales utilizadas por los habitantes del área rural de la parroquia San Carlos, Quevedo, Ecuador. Univ Salud. 2015;7(1):97-111.
60. Zamora JD. Antioxidantes: micronutrientes en lucha por la salud. Rev Chil Nutr. 2007;34(1):17-26.
61. Zendeja G, Avalos H, Soto M. Microbiología general de Staphylococcus aureus: generalidades, patogenicidad y métodos de identificación. Rev Biomédica. 2014;25(2):129-43.
62. Zendejas G, Ávalos H, Soto M. Microbiología general de Staphylococcus aureus: generalidades, patogenicidad y métodos de identificación. Rev Biomédica. 2014;25(3):129-43.
63. Zohea F, Meriem S, Samira S. Fatty acids profile and antimicrobial activities of the seed oil of Malva sylvestris L. from Algeria. Int J Chem. 2013;1(2):233-5.
FINANCIACIÓN
Ninguna.
CONFLICTO DE INTERÉS
Los autores declaran que no existe conflicto de interés.
CONTRIBUCIÓN DE AUTORÍA
Conceptualización: Yesenia Anabell Abrigo Alvarado, Nixon Michael Goyes García, Patricia Jiménez Granizo, Glenda Sarmiento Tomalá.
Curación de datos: Yesenia Anabell Abrigo Alvarado, Nixon Michael Goyes García, Patricia Jiménez Granizo, Glenda Sarmiento Tomalá.
Análisis formal: Yesenia Anabell Abrigo Alvarado, Nixon Michael Goyes García, Patricia Jiménez Granizo, Glenda Sarmiento Tomalá.
Investigación: Yesenia Anabell Abrigo Alvarado, Nixon Michael Goyes García, Patricia Jiménez Granizo, Glenda Sarmiento Tomalá.
Metodología: Yesenia Anabell Abrigo Alvarado, Nixon Michael Goyes García, Patricia Jiménez Granizo, Glenda Sarmiento Tomalá.
Administración del proyecto: Yesenia Anabell Abrigo Alvarado, Nixon Michael Goyes García, Patricia Jiménez Granizo, Glenda Sarmiento Tomalá.
Recursos: Yesenia Anabell Abrigo Alvarado, Nixon Michael Goyes García, Patricia Jiménez Granizo, Glenda Sarmiento Tomalá.
Software: Yesenia Anabell Abrigo Alvarado, Nixon Michael Goyes García, Patricia Jiménez Granizo, Glenda Sarmiento Tomalá.
Supervisión: Yesenia Anabell Abrigo Alvarado, Nixon Michael Goyes García, Patricia Jiménez Granizo, Glenda Sarmiento Tomalá.
Validación: Yesenia Anabell Abrigo Alvarado, Nixon Michael Goyes García, Patricia Jiménez Granizo, Glenda Sarmiento Tomalá.
Visualización: Yesenia Anabell Abrigo Alvarado, Nixon Michael Goyes García, Patricia Jiménez Granizo, Glenda Sarmiento Tomalá.
Redacción – borrador original: Yesenia Anabell Abrigo Alvarado, Nixon Michael Goyes García, Patricia Jiménez Granizo, Glenda Sarmiento Tomalá.
Redacción – revisión y edición: Yesenia Anabell Abrigo Alvarado, Nixon Michael Goyes García, Patricia Jiménez Granizo, Glenda Sarmiento Tomalá.